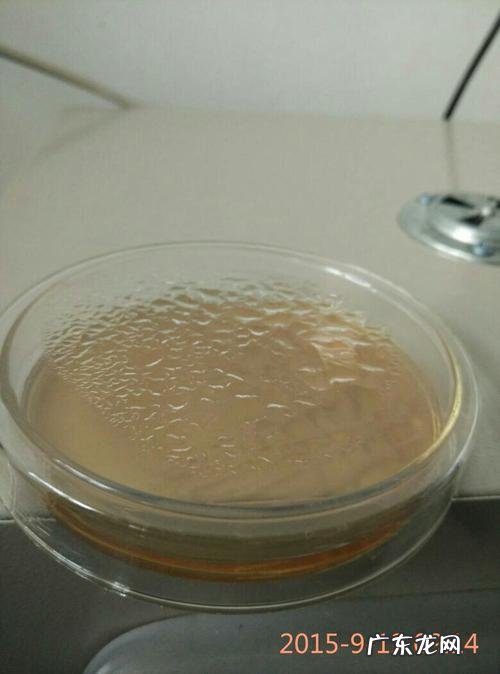

【如何防止培养皿上的水蒸气】
文章插图
空气培养皿的放置时间:一般放48小时 。
- 培养皿和培养基的区别是什么
- 消毒完了的培养皿怎么保存
- 沉香的现在价格是多少?如何辨别真假沉香?
- 如何让iPhone变得更加流畅
- 如何让你的猫变得更胖?
- 如何帮助猫咪学会使用猫砂盆?
- 如何把手机上的文件弄到电脑上
- 如何正确喂养半个月大的幼猫?
- 如何做出最正宗的糖醋茄子?
- 如何在电脑中添加防黑加固功能
特别声明:本站内容均来自网友提供或互联网,仅供参考,请勿用于商业和其他非法用途。如果侵犯了您的权益请与我们联系,我们将在24小时内删除。
